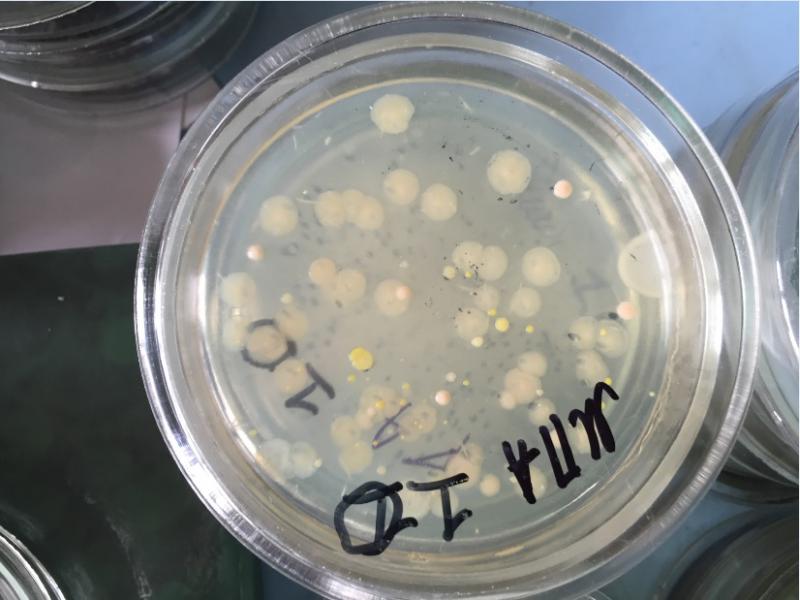
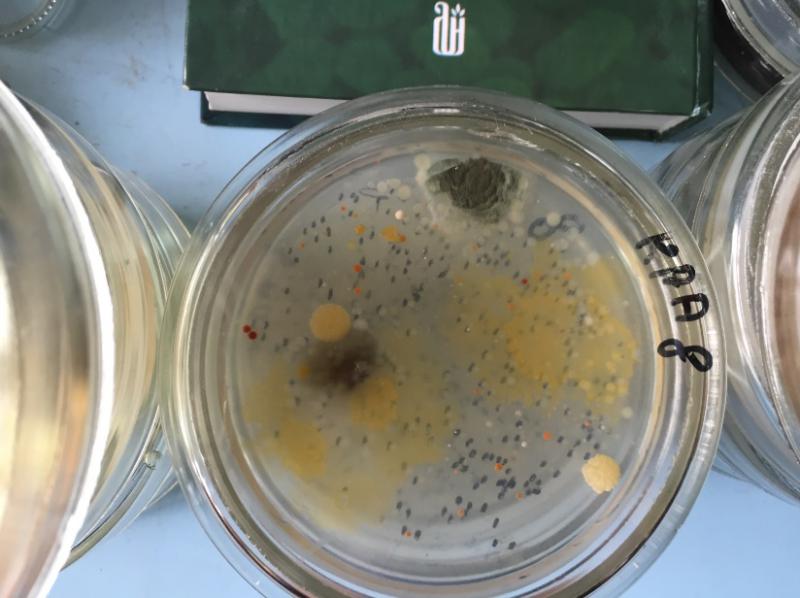

Виїзні заняття для магістрантів ННІ лісового і садово-паркового господарства в Інституті мікробіології і вірусології ім. Д.К. Заболотного НАН України
Normal
0
21
false
false
false
UK
X-NONE
X-NONE
DefSemiHidden="false" DefQFormat="false" DefPriority="99"
LatentStyleCount="371">
UnhideWhenUsed="true" QFormat="true" Name="heading 2" >
UnhideWhenUsed="true" QFormat="true" Name="heading 3" >
UnhideWhenUsed="true" QFormat="true" Name="heading 4" >
UnhideWhenUsed="true" QFormat="true" Name="heading 5" >
UnhideWhenUsed="true" QFormat="true" Name="heading 6" >
UnhideWhenUsed="true" QFormat="true" Name="heading 7" >
UnhideWhenUsed="true" QFormat="true" Name="heading 8" >
UnhideWhenUsed="true" QFormat="true" Name="heading 9" >
Name="index 1" >
Name="index 2" >
Name="index 3" >
Name="index 4" >
Name="index 5" >
Name="index 6" >
Name="index 7" >
Name="index 8" >
Name="index 9" >
UnhideWhenUsed="true" Name="toc 1" >
UnhideWhenUsed="true" Name="toc 2" >
UnhideWhenUsed="true" Name="toc 3" >
UnhideWhenUsed="true" Name="toc 4" >
UnhideWhenUsed="true" Name="toc 5" >
UnhideWhenUsed="true" Name="toc 6" >
UnhideWhenUsed="true" Name="toc 7" >
UnhideWhenUsed="true" Name="toc 8" >
UnhideWhenUsed="true" Name="toc 9" >
Name="Normal Indent" >
Name="footnote text" >
Name="annotation text" >
Name="header" >
Name="footer" >
Name="index heading" >
UnhideWhenUsed="true" QFormat="true" Name="caption" >
Name="table of figures" >
Name="envelope address" >
Name="envelope return" >
Name="footnote reference" >
Name="annotation reference" >
Name="line number" >
Name="page number" >
Name="endnote reference" >
Name="endnote text" >
Name="table of authorities" >
Name="macro" >
Name="toa heading" >
Name="List" >
Name="List Bullet" >
Name="List Number" >
Name="List 2" >
Name="List 3" >
Name="List 4" >
Name="List 5" >
Name="List Bullet 2" >
Name="List Bullet 3" >
Name="List Bullet 4" >
Name="List Bullet 5" >
Name="List Number 2" >
Name="List Number 3" >
Name="List Number 4" >
Name="List Number 5" >
Name="Closing" >
Name="Signature" >
UnhideWhenUsed="true" Name="Default Paragraph Font" >
Name="Body Text" >
Name="Body Text Indent" >
Name="List Continue" >
Name="List Continue 2" >
Name="List Continue 3" >
Name="List Continue 4" >
Name="List Continue 5" >
Name="Message Header" >
Name="Salutation" >
Name="Date" >
Name="Body Text First Indent" >
Name="Body Text First Indent 2" >
Name="Note Heading" >
Name="Body Text 2" >
Name="Body Text 3" >
Name="Body Text Indent 2" >
Name="Body Text Indent 3" >
Name="Block Text" >
Name="Hyperlink" >
Name="FollowedHyperlink" >
Name="Document Map" >
Name="Plain Text" >
Name="E-mail Signature" >
Name="HTML Top of Form" >
Name="HTML Bottom of Form" >
Name="Normal (Web)" >
Name="HTML Acronym" >
Name="HTML Address" >
Name="HTML Cite" >
Name="HTML Code" >
Name="HTML Definition" >
Name="HTML Keyboard" >
Name="HTML Preformatted" >
Name="HTML Sample" >
Name="HTML Typewriter" >
Name="HTML Variable" >
Name="Normal Table" >
Name="annotation subject" >
Name="No List" >
Name="Outline List 1" >
Name="Outline List 2" >
Name="Outline List 3" >
Name="Table Simple 1" >
Name="Table Simple 2" >
Name="Table Simple 3" >
Name="Table Classic 1" >
Name="Table Classic 2" >
Name="Table Classic 3" >
Name="Table Classic 4" >
Name="Table Colorful 1" >
Name="Table Colorful 2" >
Name="Table Colorful 3" >
Name="Table Columns 1" >
Name="Table Columns 2" >
Name="Table Columns 3" >
Name="Table Columns 4" >
Name="Table Columns 5" >
Name="Table Grid 1" >
Name="Table Grid 2" >
Name="Table Grid 3" >
Name="Table Grid 4" >
Name="Table Grid 5" >
Name="Table Grid 6" >
Name="Table Grid 7" >
Name="Table Grid 8" >
Name="Table List 1" >
Name="Table List 2" >
Name="Table List 3" >
Name="Table List 4" >
Name="Table List 5" >
Name="Table List 6" >
Name="Table List 7" >
Name="Table List 8" >
Name="Table 3D effects 1" >
Name="Table 3D effects 2" >
Name="Table 3D effects 3" >
Name="Table Contemporary" >
Name="Table Elegant" >
Name="Table Professional" >
Name="Table Subtle 1" >
Name="Table Subtle 2" >
Name="Table Web 1" >
Name="Table Web 2" >
Name="Table Web 3" >
Name="Balloon Text" >
Name="Table Theme" >
Name="List Paragraph" >
Name="Intense Quote" >
Name="Subtle Emphasis" >
Name="Intense Emphasis" >
Name="Subtle Reference" >
Name="Intense Reference" >
UnhideWhenUsed="true" Name="Bibliography" >
UnhideWhenUsed="true" QFormat="true" Name="TOC Heading" >
Name="Grid Table 1 Light Accent 1" >
Name="Grid Table 6 Colorful Accent 1" >
Name="Grid Table 7 Colorful Accent 1" >
Name="Grid Table 1 Light Accent 2" >
Name="Grid Table 6 Colorful Accent 2" >
Name="Grid Table 7 Colorful Accent 2" >
Name="Grid Table 1 Light Accent 3" >
Name="Grid Table 6 Colorful Accent 3" >
Name="Grid Table 7 Colorful Accent 3" >
Name="Grid Table 1 Light Accent 4" >
Name="Grid Table 6 Colorful Accent 4" >
Name="Grid Table 7 Colorful Accent 4" >
Name="Grid Table 1 Light Accent 5" >
Name="Grid Table 6 Colorful Accent 5" >
Name="Grid Table 7 Colorful Accent 5" >
Name="Grid Table 1 Light Accent 6" >
Name="Grid Table 6 Colorful Accent 6" >
Name="Grid Table 7 Colorful Accent 6" >
Name="List Table 1 Light Accent 1" >
Name="List Table 6 Colorful Accent 1" >
Name="List Table 7 Colorful Accent 1" >
Name="List Table 1 Light Accent 2" >
Name="List Table 6 Colorful Accent 2" >
Name="List Table 7 Colorful Accent 2" >
Name="List Table 1 Light Accent 3" >
Name="List Table 6 Colorful Accent 3" >
Name="List Table 7 Colorful Accent 3" >
Name="List Table 1 Light Accent 4" >
Name="List Table 6 Colorful Accent 4" >
Name="List Table 7 Colorful Accent 4" >
Name="List Table 1 Light Accent 5" >
Name="List Table 6 Colorful Accent 5" >
Name="List Table 7 Colorful Accent 5" >
Name="List Table 1 Light Accent 6" >
Name="List Table 6 Colorful Accent 6" >
Name="List Table 7 Colorful Accent 6" >
12 травня професор кафедри біології лісу та мисливствознавства Гойчук А.Ф. та доцент кафедри біології лісу та мисливствознавства Розенфельд В.В. провели виїзні заняття зі студентами магістратури другого року навчання за спеціалізацією «Захист лісу».
Інститут мікробіології і вірусології ім. Д. К. Заболотного НАН України — визначний науковий центр досліджень у галузі систематики, фізіології, біохімії мікроорганізмів, біотехнології, екології і загальної вірусології. Сьогодні інститут працює за двома основними напрямками: вивчення фундаментальних основ біологічної активності мікроорганізмів і вірусів з метою її регулювання та вивчення екології, систематики мікроорганізмів і вірусів та виявлення видів і штамів для розробки біотехнологічних процесів. Традиційно фундаментальні дослідження вчених інституту стають основою для створення новітніх біотехнологій і цілого ряду технологічних процесів промисловості, сільського господарства, охорони здоров’я та захисту навколишнього середовища.
Студенти ознайомилися із сучасними підходами до діагностики та профілактики захворювань лісових деревних рослин, який базується на світовому і вітчизняному досвіді. Співробітники центру також ознайомили студентів із сучасним обладнанням, методами та методиками виконання досліджень у лабораторіях фітопатогенних бактерій